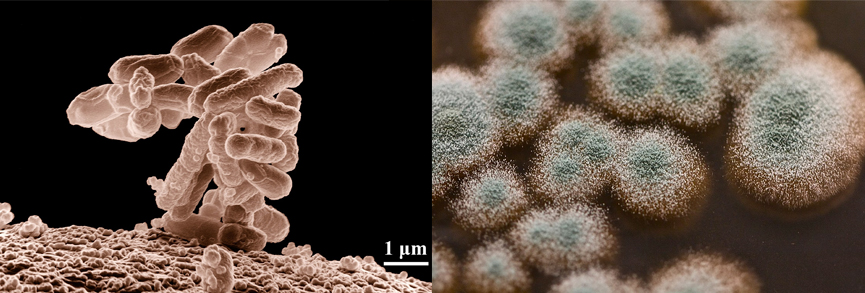

Les conservateurs ne sont pas les seuls composants destinés à protéger un produit alimentaire ou cosmétique de la dégradation: il y aussi les antioxydants (Photo Pixabay 3dman_eu).
« Nous n’avons pas besoin de conservateurs dans nos cosmétiques, puisqu’ils contiennent des vitamines A, E et C ! ». Cette affirmation, nous l’avons entendue prononcer par des commerciaux de certaines marques il y a quelques années, en pleine « crise » des parabènes. Et on continue à la voir écrite de temps à autre par certaines blogueuses qui se présentent comme « compétentes ». Cela est pourtant loin d’être le cas, et entre les « experts » autoproclamés sur le web et les exagérations marketing de quelques entreprises, le résultat est un mélange d’informations qui sont loin de refléter la réalité.
Incompétence et approximations au menu
L’exemple cosmétique cité ci-dessus en introduction illustre malheureusement l’incompétence totale de certaines personnes sur des sujets techniques. Laissons-les bénéficier de la présomption d’innocence en considérant que cela n’est pas de la malhonnêteté mais bien juste de l’incompétence. En l’occurrence, de quoi s’agissait-il ? De la polémique, à l’époque, de la dangerosité potentielle des parabènes (avérée surtout pour quelques-uns d’entre eux) et plus généralement des conservateurs, notamment du phénoxyéthanol (pour lesquels il ya également eu des amalgames déplacés). Mais à quoi sert un conservateur ? A empêcher le développement voire à tuer les germes présents dans un produit (alimentaire, cosmétique…), car ils peuvent en altérer la qualité : tout le monde a en tête à quoi peut ressembler un plat cuisiné (aspect et odeur) oublié de longs jours au fond du réfrigérateur.
Le marketing et la publicité utilisent parfois des allégations exagérées quand il s’agit de parler de l’absence de conservateurs dans un produit (Photo Pixabay Schwerdhoefer). |
Le problème est que ces germes sont des organismes vivants. Et comme tout organisme vivant, ils ont besoin de certains nutriments et micronutriments pour vivre, dont les vitamines. Or jamais une vitamine, même à dose relativement très élevée, n’a tué un organisme vivant ! Même pour la vitamine A il faut déjà 50 à 100 fois la dose quotidienne pour voir apparaître quelques effets secondaires, mais non mortels. Au contraire, dans les préparations que l’on fait pour faire pousser des germes, on ajoute des vitamines ! Les vitamines A, E et C ne sont en fait pas des conservateurs, mais des antioxydants (ou anti-oxygène), qui - comme ce nom l’indique - sont destinés à lutter contre l’oxydation, non seulement de nos cellules (d’où l’intérêt de leur présence dans notre alimentation), mais aussi de tout composé susceptible d’être dégradé par la présence d’oxygène. |
Autre exemple d’affirmation fausse, ou plutôt approximative, l’apparition depuis quelques années (justement depuis qu’existe cette méfiance quasi-généralisée à l’égard des conservateurs) d’allégations marketing vantant l’absence de conservateurs dans des produits qui, intrinsèquement, n’en on pas besoin : yaourts, salades fraîches qui se conservent juste quelques jours au réfrigérateur et autres produits dans lequel le risque de développement de germes est limité jusqu’à la date limite de consommation (et de vente) indiquée, voire inexistant (produits ne contenant pas d’eau, conserves stérilisées). Les services marketing des marques concernées ont tout simplement « surfé » sur la peur des conservateurs, peur loin d’être totalement justifiée, car il y a beaucoup de conservateurs sans risques majeurs aux doses normales d’utilisation. Il est étonnant que face à de tels cas, l’administration (Répression des Fraudes) n’ait pas réagi et dénoncé une publicité quasi-mensongère sur la forme.
A quoi servent les conservateurs ?
Comme dit plus haut, le rôle des conservateurs est d’empêcher le développement ou de tuer les germes présents dans un produit alimentaire ou cosmétique.
Car les risques sont nombreux : perte des qualités nutritives et gustatives, présence trop importante de germes perturbant notre flore intestinale (vomissements, diarrhées), développement de germes pathogènes (pouvant provoquer des maladies : ex. les germes d’origine fécale), production par les germes de produits de dégradation potentiellement nocifs (toxines), etc.
Il ne faut pas oublier que les germes susceptibles de se développer dans un produit qui est un milieu nutritif idéal pour eux (eau, protéines, sucres, lipides… vitamines) sont de différents types : les bactéries, les levures et les moisissures. Or, sur le plan de la biologie, ces organismes ne sont pas identiques. Par exemple, si l’acidité est préjudiciable aux bactéries, elle favorise à l’inverse les levures et moisissures. Ce qui signifie qu’il faut des conservateurs « à spectre large » (et donc plus « agressifs » : un conservateur « inoffensif » sur les êtres vivants n’aurait de toute façon aucun intérêt) pour pouvoir éliminer tous les types de germes. Car sinon, ce serait comme si on essayait de tuer des araignées ou des cafards avec un spray anti-moustique : aucun résultat.
Les bactéries (à g.) et les moisissures (à dr.) sont deux types différents de germes qui nécessitent un actif capable d’empêcher en même temps leur développement respectif (Photos Pixabay Wikilmages et Wikimedia Commons Tasturm).
Si en cosmétique conventionnelle, en raison de cette exigence de spectre large, des conservateurs de synthèse peu rassurants sont utilisés, les cahiers des charges de cosmétique naturelle et bio ont fait eux le choix de substances à la sécurité avérée, naturels ou nature-identique. Par exemple les acides benzoïque, dehydroacétique, salicylique, sorbique et leurs sels, l’alcool benzylique ou l’alcool éthylique (éthanol).
Dans le domaine alimentaire – et c’est là où certaines marques exagèrent dans leurs allégations – de nombreuses techniques ont été inventées, parfois depuis des millénaires, qui empêchent le développement des germes. On peut ainsi citer le fumage (viandes et charcuteries) ou l’ajout à forte dose de sel (salaisons) ou de sucre (confitures), ou encore la réfrigération ou la congélation, qui ont pour conséquence de ralentir le développement et surtout de tuer les germes, pour différentes raisons biologiques simples. Ou encore le séchage : sans eau, la plupart des germes ne peuvent pas survivre. Autre technique aussi vieille que la civilisation, la fermentation, alcoolique (vin, bière…), acétique (vinaigre) ou lactique (yaourts et fromages, saucisson sec, choucroute, nuoc-mâm, ensilage en alimentation animale…). L’alcool produit par la fermentation tue les germes, et la fermentation lactique et acétique, outre l’acidification du milieu, empêche la prolifération des germes en raison du fait que ce sont les ferments lactiques ou acétiques qui prennent le dessus. Plus récemment sont apparues la pasteurisation (semi-conserves) et la stérilisation (conserves, lait UHT…), qui tuent les germes par la chaleur. Les dernières techniques sont la conservation sous « atmosphère contrôlée » (sans oxygène) et l’ionisation (rayons gamma, interdits en bio).
Des produits qui sont obtenus par ces techniques n’ont ainsi pas besoin – normalement - de conservateurs. Les marques qui allèguent une absence de conservateurs dans ces cas ne sont donc pas vraiment sérieuses. Sachant que parfois, un conservateur est quand même rajouté, pour prolonger un peu la durée de consommation du produit : par exemple du sorbate de potassium dans les yaourts.
A ne pas confondre : les antioxydants
Les conservateurs inhibant ou détruisant les germes n’ont par contre, comme expliqué plus haut, rien à voir avec les antioxydants. Le but de ces derniers est de lutter contre l’action négative de l’oxygène. Celui-ci peut en effet oxyder de nombreux micronutriments (vitamines par exemple) et nutriments, les principaux concernés étant les lipides non saturés. Dans ce dernier cas on parle de peroxydation lipidique, les matières grasses (huiles, graisses…) concernées étant alors qualifiées de rances.
Plus un produit contient d’acides gras polyinsaturés, plus il risque de rancir (Photo Wikimedia Commons Tiia Monto). |
Un tel produit rance (alimentaire ou cosmétique, car beaucoup de produits cosmétiques contiennent bien sûr des lipides) présente une odeur très désagréable et un goût âcre. Pour les huiles et graisses, la température de cuisson à laquelle elles commencent à se dégrader (point de fumée) est abaissée. Mais cela n’est pas le risque principal : les acides gras essentiels qu’il contient sont détruits (d’où une perte de qualités nutritives) et comme avec une contamination microbienne on voit apparaître des produits de dégradation qui peuvent être nocifs, soit par ingestion, soit au contact de la peau. On assiste aussi entre autres à l’apparition de radicaux libres, dont les effets néfastes sur la santé sont bien connus depuis de nombreuses années. La lumière, une température élevée, la présence de certains métaux (cuivre et fer) peuvent accélérer l’oxydation, qui est une réaction en chaîne difficile à endiguer. |
Sont concernés tous les produits animaux ou végétaux contenant des lipides, comme le beurre ou les huiles végétales, en particulier celles très riches en acides gras polyinsaturés (acides gras essentiels), acides qui sont les plus sensibles à l’oxydation. Les poissons gras, la pâtisserie, la farine de blé entière, le riz brun, les noix et autres graines oléagineuses sont ainsi autant d’exemples susceptibles de devenir rances, ainsi que bien entendu les plats préparés et produits transformés contenant des lipides insaturés.

Les tocophérols (vitamine E) codifiés E306 (à g.) et l’acide ascorbique (vitamine C) et son sel de sodium, codifiés (E300 et E301 (à dr.), sont deux antioxydants autorisés dans les produits bio (Photos Wikimedia Commons LHcheM et Chemicalinterest).
Outre les vitamines A, E et C déjà évoquées, il existe dans la nature de nombreux antioxydants naturels, comme les polyphénols ou certains enzymes. On utilise également de nombreux dérivés de ces trois vitamines, ainsi que d’autres antioxydants naturels ou synthétiques comme l’acide lactique (E330) et ses sels de sodium et de calcium, ou encore, non autorisés en bio, les gallates (E310 à E313) ou les très décriés BHA et BHT (E320 et E321).
Pour conclure, il existe une façon très simple de distinguer les conservateurs des antioxydants dans les produits alimentaires : dans la codification européenne mise en place en 1979, les conservateurs font partie de la série des E200 et les antioxydants de celle des E300. En comparaison des près de 350 additifs autorisés en alimentation conventionnelle, toutes utilisations confondues, le règlement bio n’en tolère qu’une cinquantaine.